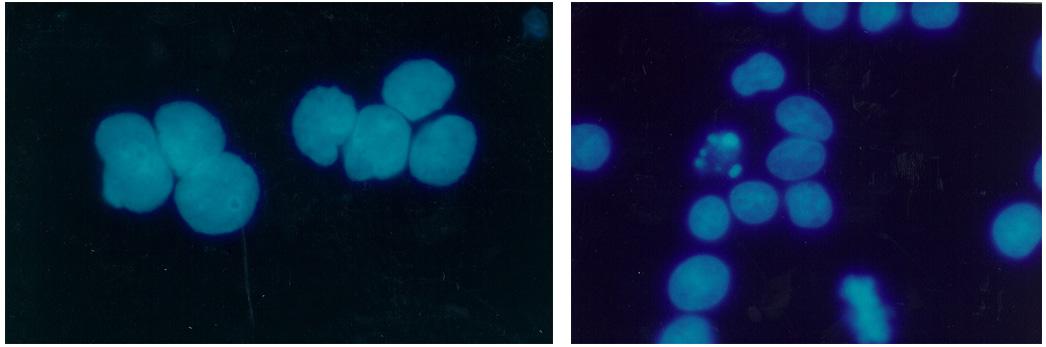
Biomedical research offers hope for a variety of medical problems, from diabetes to the replacement of damaged bone and tissues. Bioreactors, which are used to grow cells and tissue cultures, play a major role in such research and production efforts. The objective of the research was to define a way to differentiate between effects due to microgravity and those due to possible stress from non-optimal spaceflight conditions.

Neera Martin, a NASA Glenn student intern, works on a drop package for the 'Dropping in Microgravity Environment (DIME)' event held in NASA Glenn's 2.2 Second Drop Tower.

Dr. Richard DeLombard of NASA's Glenn Research Center, hands the relase line for the Microgravity Demonstrator to a visitor for her to start a short experiment showing the effects of microgravity on candle flames. Combustion physics will be a major line of investigation for NASA aboard the International Space Station (ISS). The Microgravity Demonstrator is frequently used at shows and schools to illustrate how phenomena change in microgravity. The exhibit was part of the NASA outreach activity at AirVenture 2000 sponsored by the Experimental Aircraft Association in Oshkosh, WI

Protein isolated from hen egg-white and functions as a bacteriostatic enzyme by degrading bacterial cell walls. First enzyme ever characterized by protein crystallography. It is used as an excellent model system for better understanding parameters involved in microgravity experiments with data from laboratory experiments to study the equilibrium rate of hanging drop experiments in microgravity.

Glovebox Systems Engineer, Sam Ortega, explains how the microgravity glovebox works to 2 young MSFC Open House visitors.

Crew member practices injecting seed crystals into hand-held Protein Crystallization Apparatus for Microgravity (PCAM).

(DCAM) Diffusion Controlled Crystallization Apparatus for Microgravity Trays mounted in (STES) Single Locker Thermal Enclosure System.

A versatile experiment facility for the International Space Station moved closer to flight recently with delivery of the ground-test model to NASA's Marshall Flight Center. The Microgravity Science Glovebox Ground Unit was delivered to the Microgravity Development Laboratory will be used to test hardware and procedures for the flight model of the glovebox aboard the ISS's Laboratory Module, Destiny.

After the Overnight Scentsation rose plant's return to Earth, IFF scientists found a significant change in some of the chemical components occured while in microgravity.

Advanced Automated Directional Solidification Furnace (AADSF) G-Cel with Fred Flack and Wayne Gandy in the Microgravity Development Laboratory clean room.

Middle school students learn about gravity and microgravity at the Space '98 conference in Albuquerque, New Mexico, sponsored by the American Society of Civil Engineers (ASCE).

Lysozyme crystal grown on STS-81. A protein model for documentation of the effects of microgravity on crystal growth. Principal Investigator Dan Carter of New Century Pharmaceuticals.

This photograph from CFM is a candle flame burning over time in microgravity, it shows that the candle flame continues to grow and exhibits less soot.

High school students observe the progress of the Isothermal Dendritic Growth Experiment (IDGE) during the U.S. Microgravity Payload-4 mission (STS-87, Nov. 19 - Dec. 5, 1997) at the IDGE Remote Operations Control Center (ROCC) at Rensselaer Polytechnic Institute (RPI) in Troy, NY. As part of the its outreach activity, the experiment team set up the center so students and the public could observe IDGE in progress and learn more about space and microgravity research. Photo credit: RPI

Researchers have found that as melted metals and alloys (combinations of metals) solidify, they can form with different arrangements of atoms, called microstructures. These microstructures depend on the shape of the interface (boundary) between the melted metal and the solid crystal it is forming. There are generally three shapes that the interface can take: planar, or flat; cellular, which looks like the cells of a beehive; and dendritic, which resembles tiny fir trees. Convection at this interface can affect the interface shape and hide the other phenomena (physical events). To reduce the effects of convection, researchers conduct experiments that examine and control conditions at the interface in microgravity. Microgravity also helps in the study of alloys composed of two metals that do not mix. On Earth, the liquid mixtures of these alloys settle into different layers due to gravity. In microgravity, the liquid metals do not settle, and a solid more uniform mixture of both metals can be formed.

Research with plants in microgravity offers many exciting opportunities to gain new insights and could improve products on Earth ranging from crop production to fragrances and food flavorings. The ASTROCULTURE facility is a lead commercial facility for plant growth and plant research in microgravity and was developed by the Wisconsin Center for Space Automation and Robotics (WSCAR), a NASA Commercial Space Center. On STS-95 it will support research that could help improve crop development leading to plants that are more disease resistant or have a higher yield and provide data on the production of plant essential oils---oils that contain the essence of the plant and provide both fragrance and flavoring. On STS-95, a flowering plant will be grown in ASTROCULTURE and samples taken using a method developed by the industry partner for this investigation. On Earth the samples will be analyzed by gas chromatography/mass spectrometry and the data used to evaluate both the production of fragrant oils in microgravity and in the development of one or more products.

Researchers have found that as melted metals and alloys (combinations of metals) solidify, they can form with different arrangements of atoms, called microstructures. These microstructures depend on the shape of the interface (boundary) between the melted metal and the solid crystal it is forming. There are generally three shapes that the interface can take: planar, or flat; cellular, which looks like the cells of a beehive; and dendritic, which resembles tiny fir trees. Convection at this interface can affect the interface shape and hide the other phenomena (physical events). To reduce the effects of convection, researchers conduct experiments that examine and control conditions at the interface in microgravity. Microgravity also helps in the study of alloys composed of two metals that do not mix. On Earth, the liquid mixtures of these alloys settle into different layers due to gravity. In microgravity, the liquid metals do not settle, and a solid more uniform mixture of both metals can be formed.

This photograph from CFM shows a candle flame burning over time in microgravity, it shows pieces of wax or soot moving through the flame about 25 seconds after ignition.

Jeri Briscoe of the video team inspects the optical system for proper alignment during a test run of the Equiaxed Dendritic Solidification Experiment (EDSE) located in the Microgravity Development Laboratory (MDL).

International Flavors and Fragrances Inc., Dr. Braja Mookherjee with the Overnight Scentsation rose plant after its flight aboard NASA's shuttle mission STS-95 for experimentation on scent in microgravity.

Jimmy Grisham of the Microgravity Program Plarning Integration Office at NASA/Marshall Space Flight Center, demonstrates the classroom-size Microgravity Drop Tower Demonstrator. The apparatus provides 1/6 second of microgravity for small experiments. A video camera helps teachers observe what happens inside the package. This demonstration was at the April 2000 conference of the National Council of Teachers of Mathematics (NCTM) in Chicago. Photo credit: NASA/Marshall Space Flight Center (MSFC)

The Microgravity Science Glovebox is a facility for performing microgravity research in the areas of materials, combustion, fluids and biotechnology science. The facility occupies a full ISPR, consisting of: the ISPR rack and infrastructure for the rack, the glovebox core facility, data handling, rack stowage, outfitting equipment, and a video subsystem. MSG core facility provides the experiment developers a chamber with air filtering and recycling, up to two levels of containment, an airlock for transfer of payload equipment to/from the main volume, interface resources for the payload inside the core facility, resources inside the airlock, and storage drawers for MSG support equipment and consumables.

The first International Space Station experiment facility--the Microgravity Glovebox Ground Unit--has been delivered to Marshall Space Flight Center's Microgravity Development Laboratory. The glovebox is a facility that provides a sealed work area accessed by the crew in gloves. This glovebox will be used at the Marshall laboratory throughout the Space Station era.

Dan Carter and Charles Sisk center a Lysozyme Protein crystal grown aboard the USML-2 shuttle mission. Protein isolated from hen egg-white and functions as a bacteriostatic enzyme by degrading bacterial cell walls. First enzyme ever characterized by protein crystallography. It is used as an excellent model system for better understanding parameters involved in microgravity crystal growth experiments. The goal is to compare kinetic data from microgravity experiments with data from laboratory experiments to study the equilibrium.

Research with plants in microgravity offers many exciting opportunities to gain new insights and could improve products on Earth ranging from crop production to fragrances and food flavorings. The ASTROCULTURE facility is a lead commercial facility for plant growth and plant research in microgravity and was developed by the Wisconsin Center for Space Automation and Robotics (WSCAR), a NASA Commercial Space Center. On STS-95 it will support research that could help improve crop development leading to plants that are more disease resistant or have a higher yield and provide data on the production of plant essential oils---oils that contain the essence of the plant and provide both fragrance and flavoring. On STS-95, a flowering plant will be grown in ASTROCULTURE and samples taken using a method developed by the industry partner for this investigation. On Earth, the samples will be analyzed by gas chromatography/mass spectrometry and the data used to evaluate both the production of fragrant oils in microgravity and in the development of one or more products. The ASTROCULTURE payload uses these pourous tubes with precise pressure sensing and control for fluid delivery to the plant root tray.

Space Shuttle Endeavour (STS-47) onboard photo of Astronaut Jan Davis inside the Spacelab-J module. Spacelab-J is a combined National Space Development Agency of Japan (NASDA) and NASA mission. The objectives included life sciences, microgravity and technology research.

Onboard Space Shuttle Columbia (STS-73) Payload Commander Kathryn Thornton and Commander Ken Bowersox discuss the Drop Physics Module (DPM) experiment in the United States Microgravity Laboratory 2 (USML-2) spacelab science module.

The shuttle is a reusable launch vehicle that can maintain a consistent orbit and provide up to 17 days of high-quality microgravity conditions. The shuttle, which can accomodate a wide range of experiment apparatus, provides a laboratory environment in which scientists can conduct long-term investigations.

Onboard Space Shuttle Columbia (STS-78) Mission Specialist Richard M. Lirnehan works out in the Life and Microgravity Spacelab (LMS-1) Science Module. With an almost 17-day mission away from Earth's gravity, crew members maintained an exercise regimen above and beyond their assigned LMS-1 duty assignments.

Two versions of (PCAM) Protein Crystallization Apparatus for Microgravity, (DCAM) Diffusion Controled Crystallization Apparatus is in the (STES) Single Locker Thermal Enclosure System. Principal Investigator was Dan Carter.

Space Shuttle Columbia (STS-50) astronaut Bornie Dunbar wears protective goggles to assemble a zeolite sample cartridge for the Crystal Growth Furnace (CGF) in the United States Microgravity Laboratory-1 (USML-1) science module.

STS-42, Astronauts Steve Oswald and Canadian Roberta Bondar working in IML-1 (International Microgravity Laboratory).

STS-42, Viewing earth with lots of snow, partial view of IML-1 (International Microgravity Laboratory) in cargo bay.

A Drop Tube is a long vertical shaft used for dropping experiment packages, enabling them to achieve microgravity through freefall.

Onboard Space Shuttle Columbia (STS-50) in the United States Microgravity Laboratory (USML-1) mission specialist Ellen S. Baker is hard at work.

Onboard photo of space shuttle Columbia (STS-73) cargo bay payload - the United States Microgravity Laboratory-2 (USML-2) with an earthview.

Interface Configuration Experiment on the Second United States Microgravity Laboratory (USML-2). Over time the photos show a change in the shape of the interface between a liquid and a gas in a sealed, slightly asymmetrical container. Under the force of Earth's gravity, the interface would remain nearly flat, but in microgravity, the interface shape and location changes significantly in the container, resulting in major shifts of liquid arising from small asymmetries in the container shape.

Fluid Physics is study of the motion of fluids and the effects of such motion. When a liquid is heated from the bottom to the boiling point in Earth's microgravity, small bubbles of heated gas form near the bottom of the container and are carried to the top of the liquid by gravity-driven convective flows. In the same setup in microgravity, the lack of convection and buoyancy allows the heated gas bubbles to grow larger and remain attached to the container's bottom for a significantly longer period.

The Forced Flow Flame-Spreading Test was designed to study flame spreading over solid fuels when air is flowing at a low speed in the same direction as the flame spread. Previous research has shown that in low-speed concurrent airflows, some materials are more flammable in microgravity than earth. This image shows a 10-cm flame in microgravity that burns almost entirely blue on both sides of a thin sheet of paper. The glowing thermocouple in the lower half of the flame provides temperature measurements.

Don Gillies, a materials scientist at NASA/Marshall Space Flight Center (MSFC), demonstrates the classroom-size Microgravity Drop Tower Demonstrator. The apparatus provides 1/6 second of microgravity for small experiments. A video camera helps teachers observe what happens inside the package. This demonstration was at the April 2000 conference of the National Council of Teachers of Mathematics (NCTM) in Chicago. Photo credit: NASA/Marshall Space Flight Center (MSFC)

Composite of Marshall Space Flight Center's Low-Gravity Free Fall Facilities.These facilities include a 100-meter drop tower and a 100-meter drop tube. The drop tower simulates in-flight microgravity conditions for up to 4.2 seconds for containerless processing experiments, immiscible fluids and materials research, pre-flight hardware design test and flight experiment simulation. The drop tube simulates in-flight microgravity conditions for up to 4.6 seconds and is used extensively for ground-based microgravity convection research in which extremely small samples are studied. The facility can provide deep undercooling for containerless processing experiments that require materials to remain in a liquid phase when cooled below the normal solidification temperature.

Onboard Space Shuttle Columbia (STS-73) Payload Commander Kathryn Thornton works with the Drop Physics Module (DPM) in the United States Microgravity Laboratory 2 (USML-2) Spacelab Science Module cleaning the experiment chamber of the DPM.

Onboard Space Shuttle Columbia (STS-87) mid-deck, Leonid Kadenyuk, Ukrainian payload specialist, works with the Brassica rapa plants being grown for the Collaborative Ukrainian Experiment (CUE). Kadenyuk joined five astronauts for 16-days in Earth-orbit in support of the United States Microgravity Payload 4 (USMP-4) mission.

Astronaut Catherine G. Coleman, mission specialist, checks out an Astroculture sample on the mid-deck of the Earth-orbiting Space Shuttle Columbia. Coleman was joined by four other NASA astronauts and two guest researchers for 16 full days of in-space research in support of the United States Microgravity Laboratory (USML-2) mission.

Onboard Space Shuttle Columbia (STS-73) Payload Specialist Albert Sacco loads autoclaves using a power screwdriver into the Zeolite Crystal Growth (ZCG) experiment in the middeck for the United States Microgravity Laboratory 2 (USML-2) Spacelab mission.

Space Shuttle Endeavour (STS-47) onboard photo of Astronaut N. Jan Davis at work at the Continuous Heating Furnace (CHF) in the Spacelab-J Science Module. Spacelab-J is a combined National Space Development Agency of Japan (NASDA) and NASA mission. The objectives included life sciences, microgravity and technology research.

Astronaut Carl E. Walz, mission specialist, enters the International Microgravity Laboratory (IML-2) science module in the cargo bay via the turnel connecting it to Columbia's cabin. Walz joined five other NASA astronauts and a Japanese payload specialist for more than two weeks of experimenting in Earth orbit.

Manual activation of 8 FPAs in an earlier version of the Group Activation Pack. The Fluids Processing Apparatus is essentially a microgravity test tube that allows a variety of complex investigations to be performed in space. Developed by BioServe Space Technologies, a NASA Commercial Space Center. Flown on STS-95.

BioServe researcher Dr. Yi Li first flew plant experiments on board STS-63. Li discovered that exposure to microgravity increased a particular hormone concentration in plants. Since that time, Li has been able to manipulate this phenomenon and grow fruits, such as tomatoes, that overproduce the hormone, and these plants bear larger seedless fruit in the absence of pollination.

Some of the earliest concerns about fluid behavior in microgravity was the management of propellants in spacecraft tanks as they orbited the Earth. On the ground, gravity pulls a fluid to a bottom of a tank (ig, left). In orbit, fluid behavior depends on surface tension, viscosity, wetting effects with the container wall, and other factors. In some cases, a propellant can wet a tank and leave a large gas bubbles in the center (ug, right). Similar probelms can affect much smaller experiments using fluids in small spaces. Photo credit: NASA/Glenn Research Center.

The Equiaxed Dendritic Solidification Experiment (EDSE) is a material sciences investigation under the Formation of Microstructures/pattern formation discipline. The objective is to study the microstructural evolution of and thermal interactions between several equiaxed crystals growing dendritically in a supercooled melt of a pure and transparent substance under diffusion controlled conditions. This image shows the overview for the EDSE in the Microgravity Development Lab (MDL).

STS-94 Payload Specialist Roger K. Crouch is helped into his launch/entry suit by a suit technician in the Operations and Checkout (OC) building after the suit has been given a pressure test. He is the Chief Scientist of the NASA Microgravity Space and Applications Division. He also has served as a Program Scientist for previous missions and is an expert in semiconductor crystal growth. Crouch and six other crewmembers prepare to depart the OC and head for Launch Pad 39a, where the Space Shuttle Columbia will lift off.

The Equiaxed Dendritic Solidification Experiment (EDSE) is a material sciences investigation under the Formation of Microstructures/pattern formation discipline. The objective is to study the microstructural evolution of and thermal interactions between several equiaxed crystals growing dendritically in a supercooled melt of a pure and transparent substance under diffusion controlled conditions. Video and power rack for the EDSE in the Microgravity Development Lab (MDL).

The Equiaxed Dendritic Solidification Experiment (EDSE) is a material sciences investigation under the Formation of Microstructures/pattern formation discipline. The objective is to study the microstructural evolution of and thermal interactions between several equiaxed crystals growing dendritically in a supercooled melt of a pure and transparent substance under diffusion controlled conditions. Dendrites growing at .4 supercooling from a 2 stinger growth chamber for the EDSE in the Microgravity Development Lab (MDL).

The Equiaxed Dendritic Solidification Experiment (EDSE) is a material sciences investigation under the Formation of Microstructures/pattern formation discipline. The objective is to study the microstructural evolution of and thermal interactions between several equiaxed crystals growing dendritically in a supercooled melt of a pure and transparent substance under diffusion controlled conditions. This image shows the isothermal bath and video system for the EDSE in the Microgravity Development Lab (MDL).

The Equiaxed Dendritic Solidification Experiment (EDSE) is a material sciences investigation under the Formation of Microstructures/pattern formation discipline. The objective is to study the microstructural evolution of and thermal interactions between several equiaxed crystals growing dendritically in a supercooled melt of a pure and transparent substance under diffusion controlled conditions. EDSE/TDSE project engineer, Zena Hester, monitors a test run of the EDSE located in the Microgravity Development Laboratory (MDL).

The Magnetically Damped Furnace (MDF) breadboard is being developed in response to NASA's mission and goals to advance the scientific knowledge of microgravity research, materials science, and related technologies. The objective of the MDF is to dampen the fluid flows due to density gradients and surface tension gradients in conductive melts by introducing a magnetic field during the sample processing. The MDF breadboard will serve as a proof of concept that the MDF performance requirements can be attained within the International Space Station resource constraints.

The Equiaxed Dendritic Solidification Experiment (EDSE) is a material sciences investigation under the Formation of Microstructures/pattern formation discipline. The objective is to study the microstructural evolution of and thermal interactions between several quiaxed crystals growing dendritically in a supercooled melt of a pure and transparent substance under diffusion controlled conditions. George Myers, controls engineer, monitors the thermal environment of a ground test for the EDSE located in the Microgravity Development Laboratory (MDL).

The Equiaxed Dendritic Solidification Experiment (EDSE) is a material sciences investigation under the Formation of Microstructures/pattern formation discipline. The objective is to study the microstructural evolution of and thermal interactions between several equiaxed crystals growing dendritically in a supercooled melt of a pure and transparent substance under diffusion controlled conditions. Dendrite irritator control for the EDSE in the Microgravity Development Lab (MDL).

Crystals grown in the hand-held Protein Crystallization Apparatus for Microgravity (PCAM) onboard STS-61C. The PCAM has a pedestal in the center of a circular chamber, the surrounding chamber holds an absorbent reservoir that contains a solution of the precipitant. Vapor pressure differences between the protein solution and the reservoir solution force water to move from the protein solution to the reservoir. As protein concentrations increase, protein crystals begin to nucleate and grow.

Zeolites are crystalline aluminosilicates that have complex framework structures. However, there are several features of zeolite crystals that make unequivocal structure determinations difficult. The acquisition of reliable structural information on zeolites is greatly facilitated by the availability of high-quality specimens. For structure determinations by conventional diffraction techniques, large single-crystal specimens are essential. Alternatively, structural determinations by powder profile refinement methods relax the constraints on crystal size, but still require materials with a high degree of crystalline perfection. Studies conducted at CAMMP (Center for Advanced Microgravity Materials Processing) have demonstrated that microgravity processing can produce larger crystal sizes and fewer structural defects relative to terrestrial crystal growth. Principal Investigator: Dr. Albert Sacco

Onboard Space Shuttle Columbia (STS-50) payload commander Bornie Dunbar performs life science experiments on crewmember payload specialist Lawrence Delucas in the United States Microgravity Laboratory (USML-1) science module.

Ampoule view of the Vapor Crystal Growth System (VCGS) Furnace. Used on IML-1 International Microgravity Laboratory Spacelab 3. Prinicipal Investigator and Payload Specialist was Lodewijk van den Berg.

Onboard photo of space shuttle Columbia (STS-75) Swiss crewmember Claude Nicollier with a view of Middeck Glovebox (MGBX) which provides a general-purpose enclosed workspace to carry out small-scale microgravity science experiments.

Astronaut Kathryn C. Thornton, payload commander, works at the Drop Physics Module (DPM) on the portside of the science module supporting the U.S. Microgravity Laboratory (USML-2). Astronaut Kerneth D. Bowersox, mission commander, looks on.

Space Shuttle Columbia (STS-65) onboard photo of Payload specialist Richard J. Hieb (right) and Shuttle Pilot James D. Halsell Jr. working on experiments in the Spacelab in the International Microgravity Laboratory (IML-2).

Overall view of the Vapor Crystal Growth System (VCGS) Furnace. Used on IML-1 International Microgravity Laboratory Spacelab 3. Principal Investigator and Payload Specialist was Lodewijk van den Berg.

The Advanced Automated Directional Solidification Furnace (AADSF) with the Experimental Apparatus Container (EAC) removed flew during the USMP-2 mission. During USMP-2, the AADSF was used to study the growth of mercury cadmium telluride crystals in microgravity by directional solidification, a process commonly used on earth to process metals and grow crystals. The furnace is tubular and has three independently controlled temperature zones . The sample travels from the hot zone of the furnace (1600 degrees F) where the material solidifies as it cools. The solidification region, known as the solid/liquid interface, moves from one end of the sample to the other at a controlled rate, thus the term directional solidification.

The manipulation of organic materials--cells, tissues, and even living organisms--offers many exciting possibilities for the future from organic computers to improved aquaculture. Commercial researchers are using the microgravity environment to produce large near perfect protein crystals Research on insulin has yielded crystals that far surpass the quality of insulin crystals grown on the ground. Using these crystals industry partners are working to develop new and improved treatments for diabetes. Other researchers are exploring the possibility of producing antibiotics using plant cell cultures which could lead to both orbital production and the improvement of ground-based antibiotic production.

The Commercial Vapor Diffusion Apparatus will be used to perform 128 individual crystal growth investigations for commercial and science research. These experiments will grow crystals of several different proteins, including HIV-1 Protease Inhibitor, Glycogen Phosphorylase A, and NAD Synthetase. The Commercial Vapor Diffusion Apparatus supports multiple commercial investigations within a controlled environment. The goal of the Commercial Protein Crystal Growth payload on STS-95 is to grow large, high-quality crystals of several different proteins of interest to industry, and to continue to refine the technology and procedures used in microgravity for this important commercial research.

The Advanced Automated Directional Solidification Furnace (AADSF) flew during the USMP-2 mission. During USMP-2, the AADSF was used to study the growth of mercury cadmium telluride crystals in microgravity by directional solidification, a process commonly used on earth to process metals and grow crystals. The furnace is tubular and has three independently controlled temperature zones. The sample travels from the hot zone of the furnace (1600 degrees F) where the material solidifies as it cools. The solidification region, known as the solid/liquid interface, moves from one end of the sample to the other at a controlled rate, thus the term directional solidification.

Marshall Space Flight Center's researchers have conducted suborbital experiments with ZBLAN, an optical material capable of transmitting 100 times more signal and information than silica fibers. The next step is to process ZBLAN in a microgravity environment to stop the formation of crystallites, small crystals caused by a chemical imbalances. Scientists want to find a way to make ZBLAN an amorphous (without an internal shape) material. Producing a material such as this will have far-reaching implications on advanced communications, medical and manufacturing technologies using lasers, and a host of other products well into the 21st century.

Onboard photo of space shuttle Columbia (STS-73) crewmembers Fred Leslie (foreground) and Catherine Coleman aboard the United States Microgravity Laboratory (USML) conducting experiments in a microgravitational environment available in the Orbiter's cargo bay while in low earth orbit.

On the Space Shuttle Orbiter Atlantis' middeck, Astronaut Donald R. McMonagle, mission commander, works with the Heat Pipe Performance (HPP-2) experiment during STS-66 mission. HPP-2 was flown to investigate the thermal performance and fluid dynamics of heat pipes operating with asymmetric and multiple heating zones under microgravity condition.

Onboard Space Shuttle Columbia (STS-62) Mission specialist Charles D. (Sam) Gemar works with the Middeck 0-Gravity Dynamics Experiment (MODE). The reusable test facility is designed to study the nonlinear, gravity-dependent behavior of liquids and skewed space structures in the microgravity environment.

Onboard Space Shuttle Columbia (STS-73) Mission Specialists Catherine Cady Coleman works at the glovebox facility in support of the Protein Crystal Growth Glovebox (PCG-GBX) experiment in the United States Microgravity Laboratory 2 (USML-2) Spacelab science module.

Onboard Space Shuttle Columbia (STS-87) Mission Commander Kevin R. Kregel sets up the mid-deck glove box during early hours of the 16-day United States Microgravity Payload 4 (USMP-4) mission. Kregel was joined by four other astronauts and a Ukrainian payload specialist for the mission.

Space Shuttle Endeavour (STS-47) onboard photo of Astronaut Mae Jemison working in Spacelab-J module. Spacelab-J is a combined National Space Development Agency of Japan (NASDA) and NASA mission. The objectives included life sciences, microgravity and technology research.

Onboard Space Shuttle Columbia (STS-50) all work and no play make commander Richard (Dick) Richards and payload commander Bornie Dunbar take a break from their work in the United States Microgravity Laboratory (USML-1) responsibilities.

Astronaut Kathryn C. Thornton, payload commander, works in the glovebox of the science module supporting the U.S. Microgravity Laboratory (USML-2) mission. Five NASA astronauts and two payload specialists are in the last few days of a scheduled 16 day mission.

This wide view gives an overall perspective of the working environment of five astronauts and two guest researchers for 16 days in Earth-orbit. At work in support of the U.S. Microgravity Laboratory (USML-2) mission in this particular scene are astronaut Catherine G. Coleman, who busies herself at the glovebox, and payload specialist Fred. W. Leslie, monitoring the Surface-Tension-Driven Convection Experiment (STDCE).
Biomedical research offers hope for a variety of medical problems, from diabetes to the replacement of damaged bone and tissues. Bioreactors, which are used to grow cells and tissue cultures, play a major role in such research and production efforts. The objective of the research was to define a way to differentiate between effects due to microgravity and those due to possible stress from non-optimal spaceflight conditions.

The objective of this facility is to investigate the potential of space grown semiconductor materials by the vapor transport technique and develop powdered metal and ceramic sintering techniques in microgravity. The materials processed or developed in the SEF have potential application for improving infrared detectors, nuclear particle detectors, photovoltaic cells, bearing cutting tools, electrical brushes and catalysts for chemical production. Flown on STS-60 Commercial Center: Consortium for Materials Development in Space - University of Alabama Huntsville (UAH)

Ecomaster, an affiliate of BioServe Space Technologies, this PentaPure technology has been used to purify water for our nation's Space Shuttle missions since 1981. WTC-Ecomaster of Mirneapolis, Minnesota manufactures water purification systems under the brand name PentaPure (TM). BioServe researcher Dr. George Marchin, of Kansas State University, first demonstrated the superiority of this technology and licensed it to WTC. Marchin continues to perform microgravity research in the development of new technologies for the benefit of life on Earth.

Onboard photo of space shuttle Columbia's (STS-75) open cargo bay carrying the United States Microgravity Payload-3 (USMP-3) at night.

STS-87 Onboard Photo: The U. S. Microgravity Payload-4 (USMP-4) is carried aboard multi-purpose experiment support structures mounted in the shuttle payload bay and sparning the width of the orbiter.

Biomedical research offers hope for a variety of medical problems, from diabetes to the replacement of damaged bone and tissues. Bioreactors, which are used to grow cells and tissue cultures, play a major role in such research and production efforts. The objective of the research was to define a way to differentiate between effects due to microgravity and those due to possible stress from non-optimal spaceflight conditions. These Jurkat cells, a human acute T-cell leukemia was obtained to evaluate three types of potential experimental stressors: a) Temperature elevation; b) Serum starvation; and c) Centrifugal force. The data from previous spaceflight experiments showed that actin filaments and cell shape are significantly different for the control. These normal cells serve as the baseline for future spaceflight experiments.

CGBA, a facility developed by BioServe Space Technologies, a NASA Commercial Generic Bioprocessing Space Center, allows a variety of sophisticated bioprocessing research to be performed using a common device. The Fluids Processing Apparatus is essentially a microgravity test tube that allows a variety of complex investigations to be performed in space. This is a glass barrel containing several chambers separated by rubber stoppers. Eight FPAs are placed together in a Group Activation Pack (GAP), which allows all of the research to be started simultaneously by turning a single crank. Eight GAPs, or similar-sized payloads, can be stored in a single CGBA temperature controlled locker, which now uses motor drives to automatically turn the cranks to start and stop experiments. On STS-95, research efforts cover eight major areas that will benefit Earth-based products ranging from the production of pharmaceuticals to fish hatcheries.

Researcher Dr. Yi Li developed a technique to manipulate certain characteristics of plant growth such as anit-senescence. For example, the tobacco leaf was clipped from a transgenic plant (right), and a wildtype plant (left). During ground-based laboratory studies, both leaves were left in a darkened area for 4 months. When retrieved, the wildtype plant leaf was dried-out and the transgenic leaf remained fresh and green. A variation of this technology that involves manipulating plant hormones has been conducted in space-based studies on tomato plants through BioServe Space Technologies. The transport and distribution of auxin, an important plant hormone has shown to be influenced by microgravity, which could lead to improving the quality of fruits and vegetables grown on Earth.

Vapor Crystal Growth System developed in IML-1, Mercuric Iodide Crystal grown in microgravity FES/VCGS (Fluids Experiment System/Vapor Crystal Growth Facility). During the mission, mercury iodide source material was heated, vaporized, and transported to a seed crystal where the vapor condensed. Mercury iodide crystals have practical uses as sensitive X-ray and gamma-ray detectors. In addition to their excellent optical properties, these crystals can operate at room temperature, which makes them useful for portable detector devices for nuclear power plant monitoring, natural resource prospecting, biomedical applications, and astronomical observing.

The image shows a test cell of Crystal Growth experiment inside the Vapor Crystal Growth System (VCGS) furnace aboard the STS-42, International Microgravity Laboratory-1 (IML-1), mission. The goal of IML-1, a pressurized marned Spacelab module, was to explore in depth the complex effects of weightlessness of living organisms and materials processing. More than 200 scientists from 16 countires participated in the investigations.

Onboard Space Shuttle Columbia (STS-65) Mission Specialist Leroy Chiao (top) and Mission Specialist Donald A. Thomas are seen at work in the International Microgravity Laboratory 2 (IML-2) spacelab science module. The two crewmembers are conducting experiments at the IML-2 Rack 5 Biorack (BR). Chiao places a sample in the BR incubator as Thomas handles another sample inside the BR glovebox. The glovebox is used to prepare samples for BR and slow rotating centrifuge microscope (NIZEMI) experiments.

Payload specialist Albert Sacco Jr. inspects a crystal in a cylindrical autoclave on the mid-deck of the earth-orbiting space shuttle Columbia. This Zeolite Crystal Growth (ZCG) experiment was one of a few U.S. Microgravity Laboratory (USML-2) experiments that were conducted in both the Shuttle proper and its primary cargo's science module in the payload bay. Most of the experiments were conducted solely in the science module. Sacco was one of two guest researchers who joined five NASA astronauts for 16 days of Earth-orbit.

Payload specialist Fred Leslie makes use of the versatile U.S. Microgravity Laboratory (USML-2) glovebox to conduct an investigation with the Oscillatory Thermocapillary Flow Experiment (OTFE). This complement of the Surface-Tension-Driven Convection Experiment (STDCE) studies the shapes that fluid surfaces in weightless environments assume within specific containers. Leslie was one of two guest researchers who joined five NASA astronauts for 16 days of on Earth-orbit research in support of USML-2.

Bacillus thuringiensis (Bt), a natural bacteria found all over the Earth, has a fairly novel way of getting rid of unwanted insects. Bt forms a protein substance (shown on the right) that is not harmful to humans, birds, fish or other vertebrates. When eaten by insect larvae the protein causes a fatal loss of appetite. For over 25 years agricultural chemical companies have relied heavily upon safe Bt pesticides. New space based research promises to give the insecticide a new dimension in effectiveness and applicability. Researchers from the Consortium for Materials Development in Space along with industrial affiliates such as Abott Labs and Pern State University flew Bt on a Space Shuttle mission in the fall of 1996. Researchers expect that the Shuttle's microgravity environment will reveal new information about the protein that will make it more effective against a wider variety of pests.

SPD representative Steve Lambing shows the PentaPure water purification unit to some EAA visitors. The Microgravity Research and the Space Product Development Programs joined with the Johnson Space Center (JSC) for a first time ever ISS/Microgravity Research space-focused exhibit at Oshkosh AirVenture'99 from July 28-August 3, 1999. The Space Product Development (SPD) display included the STS-95 ASTROCULTURE training hardware used by John Glenn and his crewmates, a PentaPure water purfication system, and a Ford engine block.

Srujana Neelam, a researcher working at NASA’s Kennedy Space Center in Florida, programs the SciSpinner Microgravity Simulator in the Microgravity Simulation Support Facility (MSSF) inside the Neil Armstrong Operations and Checkout building on Feb. 11, 2020. The facility was developed to provide ground simulation capability to the U.S. research community in order to supplement the limited opportunities to access the International Space Station and other platforms for microgravity research. The MSSF is designed to support biological research on microorganisms, cells, tissues, small plants and small animals. The simulator provides NASA with an alternative platform for microgravity research and creates the opportunity to conduct experiments on the space station in parallel with conditions of simulated microgravity on the ground.

Interior lights give the Microgravity Science Glovebox (MSG) the appearance of a high-tech juke box. The European Space Agency (ESA) and NASA are developing the MSG for use aboard the International Space Station (ISS). Scientists will use the MSG to carry out multidisciplinary studies in combustion science, fluid physics and materials science. The MSG is managed by NASA's Marshall Space Flight Center (MSFC). Photo Credit: NASA/MSFC

This photo shows a rubber glove and its attachment ring for the Microgravity Science Glovebox (MSG) being developed by the European Space Agency (ESA) and NASA for use aboard the International Space Station (ISS). Scientists will use the MSG to carry out multidisciplinary studies in combustion science, fluid physics and materials science. The MSG is managed by NASA's Marshall Space Flight Center (MSFC). Photo Credit: NASA/MSFC

This photo shows the access through the internal airlock (bottom right) on the Microgravity Science Glovebox (MSG) being developed by the European Space Agency (ESA) and NASA for use aboard the International Space Station (ISS). Scientists will use the MSG to carry out multidisciplinary studies in combustion science, fluid physics and materials science. The MSG is managed by NASA's Marshall Space Flight Center (MSFC). Photo Credit: NASA/MSFC

Interior lights give the Microgravity Science Glovebox (MSG) the appearance of a high-tech juke box. The European Space Agency (ESA) and NASA are developing the MSG for use aboard the International Space Station (ISS). Scientists will use the MSG to carry out multidisciplinary studies in combustion science, fluid physics and materials science. The MSG is managed by NASA's Marshall Space Flight Center (MSFC). Photo Credit: NASA/MSFC